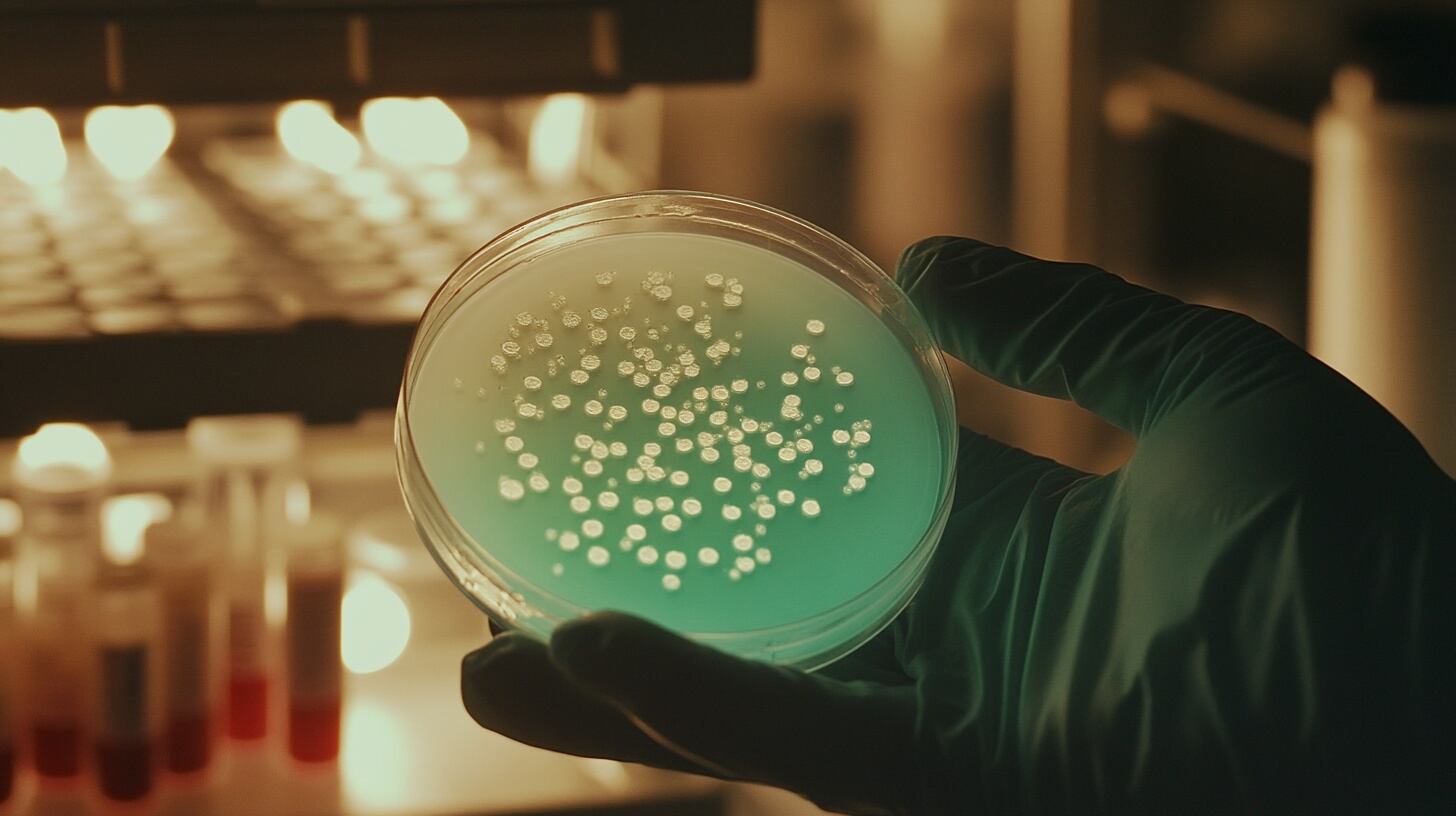
El intercambio de besos facilitó la transmisión de bacterias orales entre neandertales y humanos modernos, según el estudio.(Archivo Imagen Ilustrativa Infobae)

Antes de cualquier palabra escrita, el beso ya habría formado parte de los encuentros entre neandertales y personas modernas en Eurasia.
Un estudio realizado por científicos de la Universidad de Oxford y colegas del Reino Unido y los Estados Unidos sostiene que ambas especies habrían compartido besos hace más de 40.000 años.

Además, los investigadores afirman que ese gesto nació millones de años antes, cuando todavía no existía la humanidad tal como se la conoce en la actualidad. El trabajo fue publicado en la revista Evolution and Human Behavior.
El equipo estuvo integrado por Matilda Brindle, Catherine Talbot y Stuart West, de la Universidad de Oxford, el Colegio Universitario de Londres y el Instituto de Tecnología de Florida.
Por qué besar va más allá del amor

Para los científicos, besar no siempre tiene que ver con el amor. Se propusieron comprender si besar tenía ventajas biológicas, ayudaba a crear lazos sociales o cumplía otras funciones esenciales.
Consideraron que el beso es una acción amistosa o afectiva entre miembros de la misma especie, con contacto boca a boca, movimiento de labios y sin intercambio de alimento. Esta definición excluyó prácticas como dar comida masticada de boca a boca.

El objetivo de los investigadores fue saber si besar se inventó varias veces en la evolución o si fue una herencia de ancestros comunes de humanos, neandertales y grandes simios.
También quisieron determinar en qué circunstancias besar podía aportar beneficios, como fortalecer lazos sociales o mejorar el cuidado entre individuos.
Cómo rastrearon el inicio del beso
Para responder a esas preguntas, el estudio revisó investigaciones previas, videos y reportes sobre primates africanos y asiáticos. Sumó datos genéticos sobre bacterias presentes en la boca de humanos y neandertales.
El análisis se hizo al usar modelos estadísticos bayesianos, que permiten calcular la probabilidad de que un comportamiento existiera en antepasados ya extintos.
El equipo marcó como “presente” toda evidencia confiable de besos en primates. Si no encontraron pruebas suficientes, catalogaron la conducta como “no observada”, sin descartar que pueda existir, pero no esté documentada.
Observaron también si el beso era más frecuente en especies con costumbres sociales complejas, varias parejas o dietas variadas.
Evidencias que acercan a dos especies

La hipótesis de qué neandertales y humanos modernos compartieron besos descansa en tres pruebas principales.
Primero, los modelos evolutivos de conducta indican que el beso estaba presente en los neandertales.
En segundo lugar, los investigadores mencionaron evidencias de bacterias idénticas en la boca de ambos grupos, mantenidas durante miles de años tras su separación, lo que puede explicarse solo con contacto boca a boca.
“Los microbios orales compartidos dejan abierta la posibilidad de que humanos modernos y neandertales se hayan besado”, escribieron los investigadores.
El análisis muestra que el beso apareció primero en el ancestro de los grandes simios, hace entre 21,5 y 16,9 millones de años.
Es un gesto que no solo pertenece a las personas: chimpancés, bonobos y orangutanes también lo practican. En cada especie, besar expresa vínculos, consuelo o reconciliación.
Besar resulta común en especies de grupos mixtos y estructuras sociales flexibles. Allí ayuda a crear confianza, calmar disputas o cuidar a otros miembros, de acuerdo con los investigadores.
En ciertas especies, besar aparece muy poco o no se documenta, pero el patrón general asocia el gesto con lazos sociales duraderos y necesidades de cooperación.
Lo que falta saber sobre el beso

Los investigadores reconocieron que los análisis que hicieron “estuvieron limitados de varias maneras que pueden haber afectado nuestras conclusiones preliminares”.
La mayoría de los datos provienen de primates en zoológicos; hay menos de animales silvestres. Tampoco es posible saber cuán frecuente es el beso, ni diferenciar claramente entre tipos de besos.

Por eso, el equipo consideró que se necesitan más investigaciones que recopilen datos más detallados y comparen distintas formas de besar en animales y en personas de diferentes culturas.
Aunque faltan muchas piezas para entender por completo el pasado, el beso asoma como una costumbre que conecta a los humanos con sus ancestros y recuerda que algunos gestos logran trascender millones de años.
El doctor Jake Brooker, experto en el comportamiento de grandes simios en la Universidad de Durham, quien no participó en el trabajo, dijo al ser consultado por The Guardian que, como el comportamiento de besar se observa en una amplia variedad de simios, tiene sentido que sus orígenes estén muy atrás en nuestro pasado evolutivo, y que un análisis de diferentes formas de besar en una mayor diversidad de especies podría situar su origen aún más atrás en el tiempo.
“Cosas que consideramos propias de la vida humana, como besar, no son exclusivas nuestras si observamos de cerca a otros animales”, afirmó.